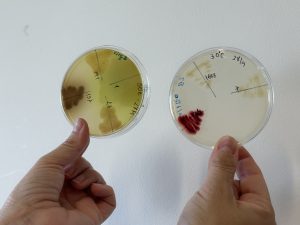

- Associação CATAA
- O CATAA
- Serviços
- Projetos
- Em curso
- Concluídos
- MEDEAT_BB
- Dinamiza CCAB
- FUSILLI
- Cultivar
- PROGRAMA DE VALORIZAÇÃO DA FILEIRA DO QUEIJO DOP NA REGIÃO CENTRO
- Pack2life
- PrunusPós
- iCheese
- F4F-Forest For Future
- I9 Factory
- INOV2B
- WinBio
- Nutrinforma
- Transfer2agro
- SOSValor
- QI PME Formação Ação + Eficiência
- 3I BIOECONOMIA
- CETEIs
- Innoace
- E. AEBB
- INOV2AGRO
- Redes Locais de Inovação
- Packaging
- Taste for Kids
- REINOVA
- MOBFOOD
- Qualifica4agro
- GOV_CCAB
- BIODIMEL
- Publicações
- Contactos